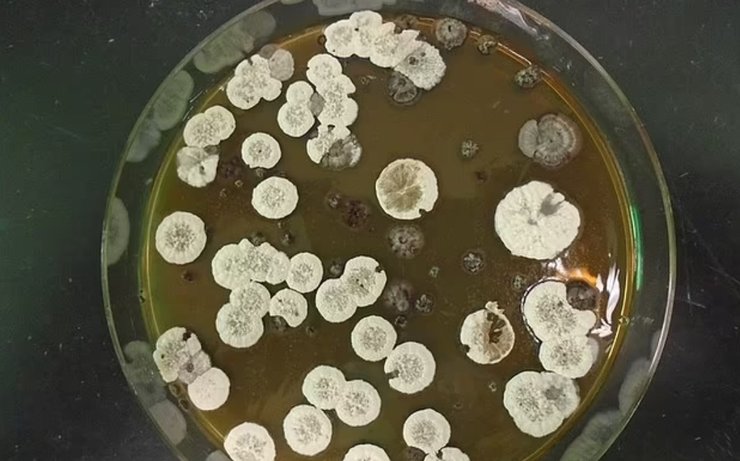
стрептомицеты

Бактерии поднимут самолеты в небо. Найден неожиданный источник альтернативного топлива

С помощью бактерий, которые обитают в почве ученые нашли новый способ поднимать самолеты в небо.
Топливо, которое производится для самолетов берет свои истоки в нефти. Этот ископаемый ресурс обязательно скоро закончится. Но еще одна причина, по которой ученые ищут способы создать альтернативное топливо – это выбросы в атмосферу из двигателей самолетов, которые влияют на глобальное потепление. Новое исследование показало, что можно создать экологически чистое топливо из бактерий, которые обитают в почве, сообщает Daily Mail.
При воспламенении топлива на основе нефти происходит выделение огромного количества энергии. Но ученые решили проверить можно ли создать тот же процесс полагаясь не на ископаемый источник топлива. Поэтому ученые обратили внимание на углеродную молекулу под названием джосамицин, которую производят обычные бактерии, живущие в почве под названием стрептомицеты.
"Рецепт альтернативного топлива уже есть в природе. Когда почвенные бактерии поглощают глюкозу или аминокислоты, они расщепляют их и превращают в строительные блоки для углеродных связей. Появляется молекула джосамицин. И эти молекулы могут создавать мощное выделение энергии", — говорит Пабло Круз-Моралес из Технического университета Дании.
По словам ученого, топливо, которое могут создавать бактерии во многом похоже на биодизель. Это топливо еще нужно обработать, чтобы при сжигании оно могло привести в движение не только самолет, но и космическую ракету.
"Если можно сделать топливо из биологических источников, то зачем создавать топливо из ископаемых источников, то есть из нефти? Нам нужно провести дополнительные исследования, чтобы с помощью этих бактерий можно было создавать топливо в промышленных масштабах. И это топливо смогут использовать самолеты", — говорит Круз-Моралес.
Но пока основная проблема заключается в том, что на пути к созданию альтернативных видов топлива стоит препятствие в виде постоянной поддержки со стороны правительств ведущих стран производства топлива из нефти, говорит ученый.
"Это политика. Наша планета зависит во многом от нефти. Но она все же закончится и придет время обратить внимание на альтернативные источники топлива. И здесь пригодится наша разработка", — говорит Круз-Моралес.
Фокус уже писал об очень необычном виде альтернативного топлива для космических ракет, которое придумали японские ученые.
Фокус также писал, что недавнее исследование показало, что некоторые виды бактерий могут перерабатывать метан и превращать его в альтернативное топливо.